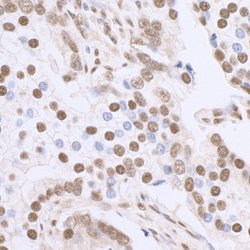
Sp1 Rabbit anti-Human, Mouse, Polyclonal, Bethyl Laboratories 100 &mu;L;

Learn More
Sp1 Rabbit anti-Human, Mouse, Polyclonal, Bethyl Laboratories
Rabbit Polyclonal Antibody
Supplier: Bethyl Laboratories, Inc A300134A

Description
The recommended shelf life for this product is 1 year from date of receipt. Application Note: For IHC, epitope retrieval with citrate buffer pH 6.0 is recommended for FFPE tissue sections.
Transcription factor that can activate or repress transcription in response to physiological and pathological stimuli. Binds with high affinity to GC-rich motifs and regulates the expression of a large number of genes involved in a variety of processes such as cell growth, apoptosis, differentiation and immune responses. Highly regulated by post-translational modifications (phosphorylations, sumoylation, proteolytic cleavage, glycosylation and acetylation). Binds also the PDGFR-alpha G-box promoter. May have a role in modulating the cellular response to DNA damage. Implicated in chromatin remodeling. Plays a role in the recruitment of SMARCA4/BRG1 on the c-FOS promoter. Plays an essential role in the regulation of FE65 gene expression.Specifications
| Sp1 | |
| Polyclonal | |
| Unconjugated | |
| SP1 | |
| SP1; Sp1 transcription factor ; HGNC:11205 | |
| Rabbit | |
| Antigen affinity chromatography | |
| RUO | |
| 20683, 6667 | |
| 4° C | |
| Liquid |
| ChIP sequencing (ChIP-seq), Immunohistochemistry, Immunoprecipitation, Western Blot | |
| 1 mg/ml | |
| phosphate, tris citrate with 0.09% sodium azide; pH 7-8 | |
| O89090, P08047 | |
| SP1 | |
| Between 750 and C-term | |
| 100 μL | |
| Primary | |
| Human, Mouse | |
| Antibody | |
| IgG |
The Fisher Scientific Encompass Program offers items which are not part of our distribution portfolio. These products typically do not have pictures or detailed descriptions. However, we are committed to improving your shopping experience. Please use the form below to provide feedback related to the content on this product.